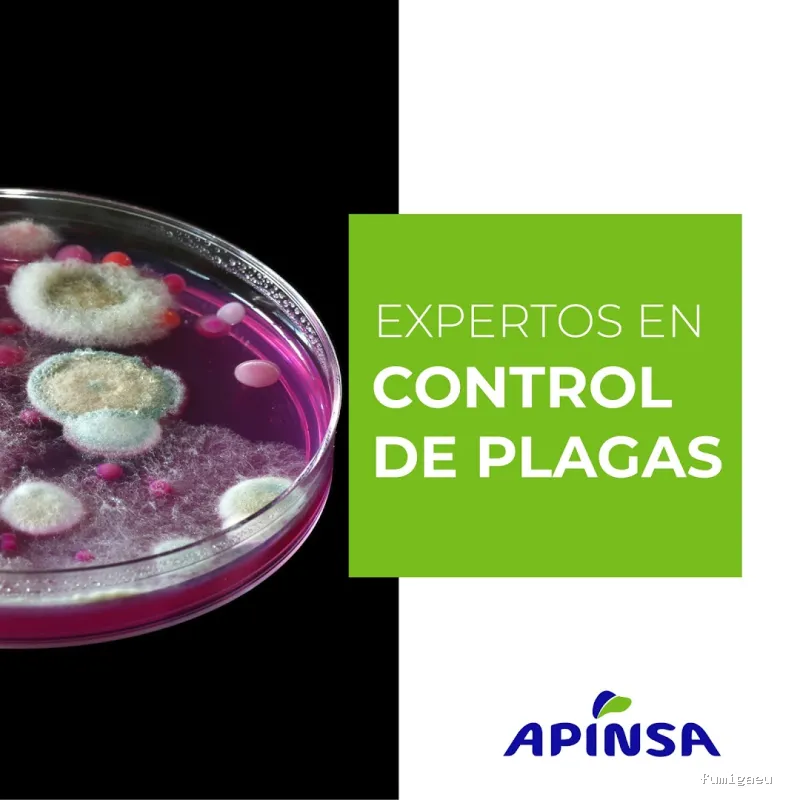
Apinsa Fuerteventura

Apinsa Fuerteventura
Empresa de fumigación y control de plagas • Puerto del Rosario
info Acerca de
APINSA es una empresa que ofrece asesoramiento en el control y erradicación de plagas, lo que redunda en la mejora de la salud pública y medioambiental, protegiendo tanto a familias como a empresas, lo que la convierte en una empresa de referencia dentro del sector de control de plagas a nivel nacional.
location_on C. Sevilla, 48, Local derecha, 35600 Puerto del Rosario, Las Palmas, España
photo_library Galería de Imágenes
Resumen de las opiniones
verified Basado en reseñas reales, resumido con IA
En particular, los clientes destacan la capacidad de la empresa para solucionar problemas de cucarachas y hormigas de manera efectiva y rápida. Algunos clientes también mencionan la buena atención recibida por parte de empleados específicos, como David Andújar y Félix Benitez. La mayoría de los clientes califica el servicio como "excepcional" y "de 10", y muchos de ellos destacan que la empresa es la mejor en su sector. No hay comentarios negativos en las reseñas, lo que sugiere que la empresa tiene una excelente reputación entre sus clientes.
En general, la experiencia de los clientes con Apinsa Fuerteventura es muy satisfactoria. La empresa parece tener un enfoque en la atención al cliente y la eficacia en su trabajo, lo que ha llevado a una gran cantidad de clientes satisfechos y leales. La falta de comentarios negativos sugiere que la empresa es capaz de manejar cualquier problema que surja de manera efectiva y mantener una buena relación con sus clientes. Esto sugiere que Apinsa Fuerteventura es una empresa confiable y recomendable para aquellos que necesitan servicios de control de plagas.
star Reseñas de Clientes
Basado en 158 reseñas
Juan Martinez
Hace 6 años
Eficaces y profesionales
Dibláyim García
Hace 6 años
JUAN S RODRIGUEZ (VNJABOGADOS)
Hace 5 años
Elisabet Urbano Felipe
Hace 4 años
Gran profesionalidad, me atendieron rapido y solucionaron el problema. Saben muy bien lo que hacen.
Carmen Hernandez Marrero
Hace 3 años
Respuesta inmediata y asesoramiento muy profesión. Gracias
Jenni Legido
Hace 2 años
Natalia Ochoa De León
Hace 2 años
Han venido a fumigar 3 veces y siguen habiendo cucarachas. Más caro que otras empresas y nada efectivo.
Jacobo camino padilla
Hace un año
Servicio muy buen. Serios y muy efectivos
beatriz de leon
Hace un año
Tengo todos mis apartamentos vacacionales y complejos turísticos con ellos.... Siempre atentos a todo problema. Cuando los llamas en 24h están en el sitio para desinfección, además super efectivos.
Antonio Jiménez
Hace un año
Sus empleados son unos profesionales y la empresa siempre está pendiente de cualquier contratiempo que podamos tener. La recomiendo sí o sí...
rate_review Deja tu Reseña
Ubicación
Aviso importante
La información mostrada en esta ficha ha sido recopilada de fuentes públicas proporcionadas por el propio negocio. Esta ficha debe servir únicamente como toma de contacto inicial. Recomendamos realizar una investigación más exhaustiva y solicitar referencias antes de contratar cualquier servicio.